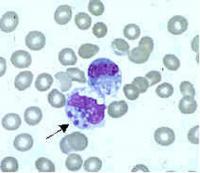

Ehrlichiosis
Bacteria from the genus Ehrlichia have long been recognized as veterinary pathogens, but the first human case of ehrlichiosis was not identified until 1986. Since that year, the number of case reports has grown fairly steadily and currently stands at around 500 per year. Although ehrlichiosis is a nationally reportable disease, reporting is passive, and the true incidence of the Ehrlichia infection is thus assumed to be significantly higher. This suspicion is bolstered by the high rates of background seroprevalence (~12-15%) in endemic areas, a finding that also indicates that many infections are mild and self-limiting or asymptomatic.
Ehrlichia are small, gram-negative bacteria, round or ellipsoidal in shape. They preferentially invade mononuclear phagocytes, such as monocytes and macrophages, and in some cases neutrophils. In all of these cell types they occupy cytoplasmic vacuoles, usually in bacterial microcolonies known as morulae. Ehrlichia cycle in nature between ticks and mammals, and can cause disease in many mammalian species.
The two known primary agents of human ehrlichiosis are E. chaffeensis and E. ewingii. (A third species, E. canis, has recently been found to infect humans, but its significance as a human pathogen is not well understood at this point.) E. chaffeensis targets monocytes and is therefore referred to as the agent of “human monocytic ehrlichiosis” (HME). In contrast, E. ewingii preferentially invades neutrophil granulocytes. In this regard, it resembles the Anaplasma pathogen A. phagocytophilum (see section on Anaplasmosis, below), the agent of human granulocytic anaplasmosis (HGA), although it is genetically and serologically much closer to E. chaffeensis. To avoid confusion with HGA, most researchers prefer to call this disease entity “human ewingii ehrlichiosis.”
E. chaffeensis is known to be transmitted by the lone star tick, Amblyomma americanum, and white tail deer appear to be its most important natural mammalian reservoir. In the United States, cases of the disease generally track the known distribution of the lone star tick, occurring throughout the south central, southeastern and mid-Atlantic states, although there have also been scattered case reports in states with no known population of these ticks, such as Montana and Utah. E. ewingii is also thought to be transmitted by lone star ticks, but less is known about its natural history and enzootic cycle.
Patients are most likely to be infected with Ehrlichia in spring and summer months, though cases occur into autumn as well. Unlike Lyme disease and Rocky Mountain spotted fever, ehrlichiosis strikes older people preferentially, probably due to immunological host factors. However, severe and even fatal cases have also been reported in children and young adults.
Signs and Symptoms
Although E. chaffeensis and E. ewingii invade different host cells, they seem to produce a similar clinical course in humans. Most patients develop symptoms one to two weeks after the tick bite, and over 70% will have fever, chills, severe headache, and myalgias. Less common symptoms include nausea and vomiting, as well as confusion. A maculopapular rash (easily distinguishable from Rocky Mountain spotted fever) can also occur. As with many other tick-borne diseases, the symptoms are largely non-specific, thus confounding diagnosis.
Although most cases of HME are uncomplicated, it is a potentially serious illness. Hospitalization rates in symptomatic patients are estimated to be 40-50%, and fatalities run in the 2-3% range. At greatest risk are patients with underlying immunosuppression, such as organ transplant recipients or HIV or cancer patients. These patients are also at increased risk for complications in human ewingii ehrlichiosis, but no fatalities have been reported for this infection.
The main complications of ehrlichiosis are prolonged fever, a toxic or septic shock-like syndrome, coagulopathy, adult respiratory distress syndrome, and central nervous system manifestations such as meningoencephalitis, seizures and coma. Peripheral neuropathies, primarily cranial neuritis, are rarer, but have also been reported.
Diagnosis
The potential severity of ehrlichial infections makes early diagnosis critical. Common findings on conventional blood tests include leukopenia, thrombocytopenia, and elevated serum transaminases, and this triad, which is also found in Rocky Mountain spotted fever, should prompt physicians to seriously consider empiric antibiotic treatment, especially if the patient is from an endemic area and has had recent tick exposure.
From the standpoint of timeliness, the most useful diagnostic test for ehrlichiosis is probably polymerase chain reaction (PCR). Sensitivity has been reported to range between 60-85% for E. chaffeensis; the sensitivity for E. ewingii infections is not known, but PCR is the only definitive diagnostic test for E. ewingii, which has so far never been cultured in vitro. PCR sensitivity is negatively affected by prior antibiotic treatment, so blood samples for PCR testing should be drawn before treatment has been initiated.
Examination of Wright-stained blood smears for the classic ehrlichial morulae colonies is clearly diagnostic for E. chaffeensis if positive in monocytes. This test can be performed rapidly, but is of limited real-world utility due to its lack of sensitivity, which rarely exceeds 25%. As with PCR, prior antibiotic therapy reduces sensitivity.
Culture of E. chaffeensis is possible from either blood or cerebrospinal fluid, but usually takes at least two weeks. Thus, this method is useful only for retrospective confirmation of the diagnosis. Similarly, changes in antibody titers detected by indirect immunofluorescent assay (IFA) during the convalescent phase can buttress the diagnosis, but this testing method is not useful during acute illness, when treatment decisions need to be formulated. Physicians should also be aware that IgG antibodies can remain high for years after the infection, and false positive results have been associated with many other conditions, including several tick-borne diseases (Lyme disease, Rocky Mountain spotted fever, and Q fever).